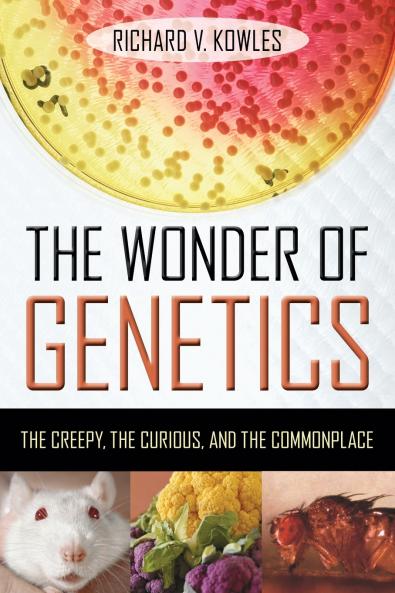
The Wonder of Genetics

English
Paperback
₹1525
₹1934
21.15% OFF
(All inclusive*)
Delivery Options
Please enter pincode to check delivery time.
*COD & Shipping Charges may apply on certain items.
Review final details at checkout.
Looking to place a bulk order? SUBMIT DETAILS
About The Book
Description
Author
This refreshingly clear layperson's overview of genetics shows how heredity actually works and how it is studied in plants and animals clearly explaining these concepts without an overload of technical jargon. The author devotes separate chapters to such popular topics as: the genetic differences between males and females the potential effects of radiation on the human genome eating irradiated or genetically modified foods cloning genetic therapy stem-cell research nature vs. nurture and how genes are related to many diseases psychological disturbances and possibly other behaviors. The book concludes by addressing common misconceptions about genetics and emphasizing the discipline's potential for curing some diseases extending human lifespan enhancing medicine and agriculture and generally improving society.
Delivery Options
Please enter pincode to check delivery time.
*COD & Shipping Charges may apply on certain items.
Review final details at checkout.
Details
ISBN 13
9781633889460
Publication Date
-01-09-2023
Pages
-346
Weight
-469 grams
Dimensions
-152x229x19.62 mm